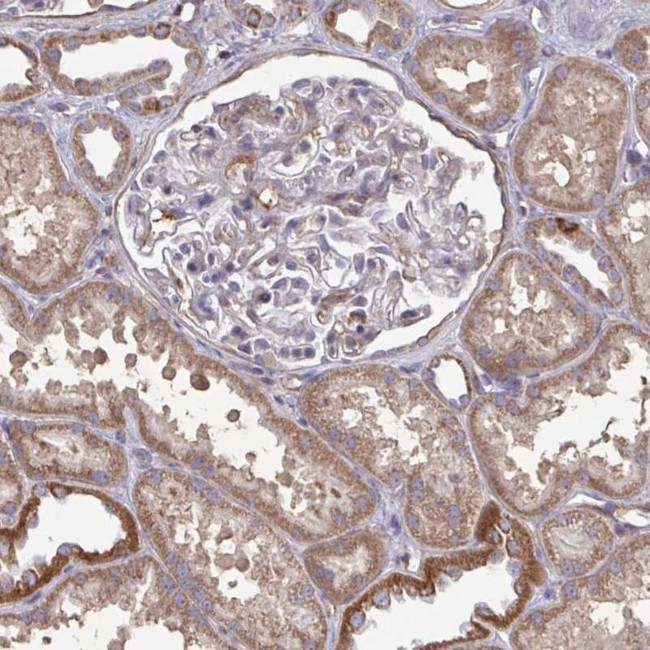
ISCU Antibody in Immunohistochemistry (IHC)

Search
Invitrogen
ISCU Polyclonal Antibody
{{$productOrderCtrl.translations['antibody.pdp.commerceCard.promotion.promotions']}}
{{$productOrderCtrl.translations['antibody.pdp.commerceCard.promotion.viewpromo']}}
{{$productOrderCtrl.translations['antibody.pdp.commerceCard.promotion.promocode']}}: {{promo.promoCode}} {{promo.promoTitle}} {{promo.promoDescription}}. {{$productOrderCtrl.translations['antibody.pdp.commerceCard.promotion.learnmore']}}
产品信息
PA5-63455
种属反应
宿主/亚型
分类
类型
抗原
偶联物
形式
浓度
规格
纯化类型
保存液
内含物
保存条件
运输条件
RRID
产品详细信息
Immunogen sequence: PARLYHKKVV DHYENPRNVG SLDKTSKNVG TGLVGAPACG DVMKLQIQVD EKGKIVDARF K
Highest antigen sequence identity to the following orthologs: Mouse - 100%, Rat - 100%.
靶标信息
Iron-sulfur (Fe-S) clusters are necessary for several mitochondrial enzymes and other subcellular compartment proteins. They contain sulfur and iron, and are created via several steps that include cysteine desulfurases, iron donors, chaperones, and scaffold proteins. This gene encodes the two isomeric forms, ISCU1 and ISCU2, of the Fe-S cluster scaffold protein. Mutations in this gene have been found in patients with myopathy with severe exercise intolerance and myoglobinuria.
仅用于科研。不用于诊断过程。未经明确授权不得转售。
篇参考文献 (0)
生物信息学
蛋白别名: Iron-sulfur cluster assembly enzyme ISCU; iron-sulfur cluster assembly enzyme ISCU, mitochondrial; iron-sulfur cluster scaffold protein; IscU iron-sulfur cluster scaffold homolog; NifU-like N-terminal domain-containing protein; NifU-like protein; unnamed protein product
基因别名: 2310020H20Rik; HML; hnifU; ISCU; ISU2; NIFU; NIFUN
UniProt ID: (Human) Q9H1K1
Entrez Gene ID: (Human) 23479